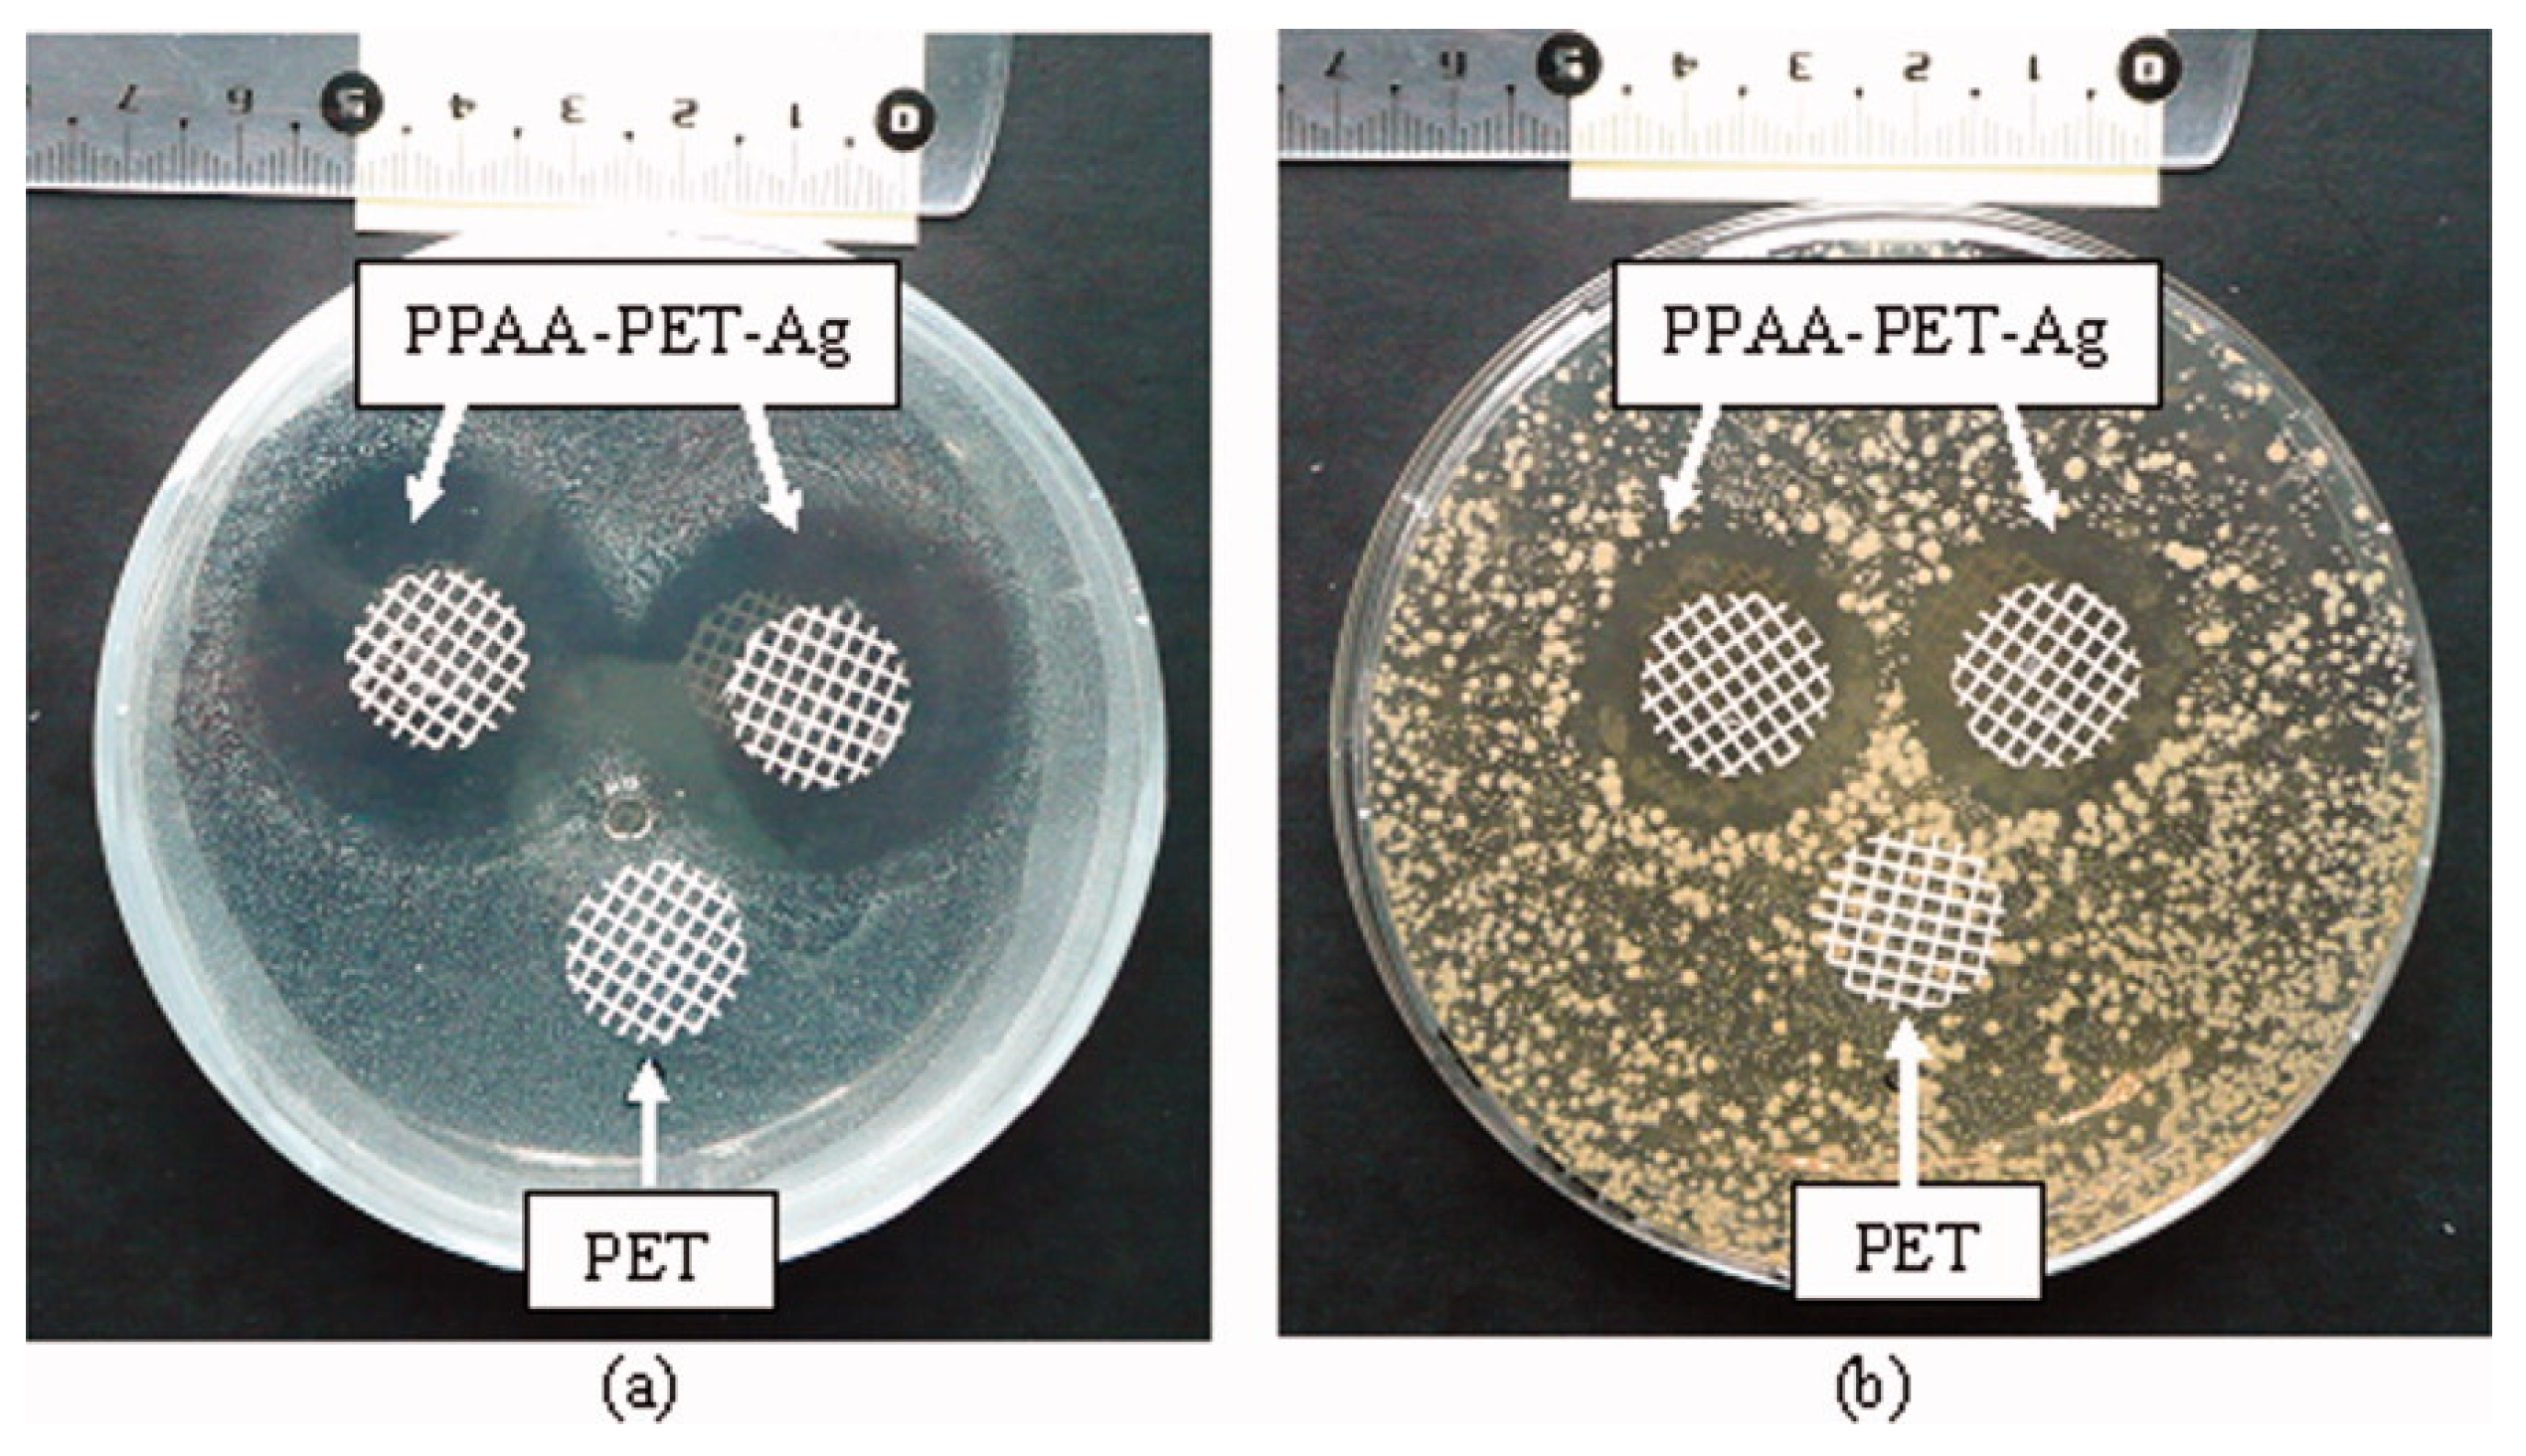
Polymers 12 02469 g004

Polymeric Coatings with Antimicrobial Activity: A Short Review
Abstract
1. Introduction
2. Polymeric Coatings
2.1. Topographic Cues
2.2. Chemical Action
3. Conclusions and Future Perspectives
Author Contributions
Funding
Acknowledgments
Conflicts of Interest
References
- Centers for Disease Control and Prevention, Office of Infectious Disease. Antibiotic resistance threats in the United States, 2019. Available online: https://www.cdc.gov/drugresistance/biggest-threats.html?CDC_AA_refVal=https%3A%2F%2Fwww.cdc.gov%2Fdrugresistance%2Fbiggest_threats.html (accessed on 9 May 2020).
- Davey, P.; Pagliari, C.; Hayes, A. The patient’s role in the spread and control of bacterial resistance to antibiotics. Clin. Microbiol. Infect. 2002, 8, 43–68. [Google Scholar] [CrossRef] [PubMed]
- Gross, M. Antibiotics in crisis. Curr. Biol. 2013, 23, R1063–R1065. [Google Scholar] [CrossRef] [PubMed]
- Bartlett, J.G.; Gilbert, D.N.; Spellberg, B. Seven ways to preserve the miracle of antibiotics. Clin. Infect. Dis. 2013, 56, 1445–1450. [Google Scholar] [CrossRef] [PubMed]
- Piddock, L.J. The crisis of no new antibiotics—What is the way forward? Lancet Infect. Dis. 2012, 12, 249–253. [Google Scholar] [CrossRef]
- Michael, C.A.; Dominey-Howes, D.; Labbate, M. The antimicrobial resistance crisis: Causes, consequences, and management. Front. Public Health 2014, 2, 145. [Google Scholar] [CrossRef]
- Alves de Silva, M.; Beddows, C.G.; Gil, M.H.; Guthrie, J.T.; Guiomar, A.J.; Kotov, S.; Piedade, A.P. The application of radiation-induced processed copolymers to biocatalysis immobilization. Radiat. Phys. Chem. 1990, 35, 98–101. [Google Scholar] [CrossRef]
- Oliveira Brett, A.M.C.F.; Gil, M.H.; Piedade, A.P. An electrochemical bienzyme membrane sensor for free cholesterol. Bioelectrochem. Bioenerg. 1992, 28, 105–115. [Google Scholar] [CrossRef]
- Piedade, A.P.; Gil, M.H.; Cavaco, M.C.; Andrade, M.E. Behaviour of catalase immobilised on poly(acrylonitrile)-g.co-hydroxyethyl methacrylate when used in a continuous system. Polym. Int. 1995, 38, 269–275. [Google Scholar] [CrossRef]
- Munoz-Bonilla, A.; Fernández-García, M. Polymeric materials with antimicrobial activity. Prog. Polym. Sci. 2012, 37, 281–339. [Google Scholar] [CrossRef]
- Chang, Y.H.; Tseng, S.R.; Chen, C.Y.; Meng, H.F.; Chen, E.C.; Horng, S.F.; Hsu, C.S. Polymer solar cell by blade coating. Org. Electron. 2009, 10, 741–746. [Google Scholar] [CrossRef]
- Lu, Y.; Ganguli, R.; Drewien, C.A.; Anderson, M.T. Continuous formation of supported cubic and hexagonal mesoporous films by sol-gel dip-coating. Nature 1997, 389, 364–368. [Google Scholar] [CrossRef]
- Choi, D.Y.; Kang, H.W.; Sung, H.J.; Kim, S.S. Annealing-free, flexible silver nanowire–polymer composite electrodes via a continuous two-step spray-coating method. Nanoscale 2013, 5, 977–983. [Google Scholar] [CrossRef] [PubMed]
- Chang, C.C.; Pai, C.L.; Chen, W.C.; Jenekhe, S.A. Spin coating of conjugated polymers for electronic and optoelectronic applications. Thin Solid Films 2005, 479, 254–260. [Google Scholar] [CrossRef]
- Chen, N.; Kim, D.H.; Kovacik, P.; Sojoudi, H.; Wang, M.; Gleason, K.K. Polymer Thin Films and Surface Modification by Chemical Vapor Deposition: Recent Progress. Annu. Rev. Chem. Biomol. Eng. 2016, 7, 373–393. [Google Scholar] [CrossRef] [PubMed]
- Piedade, A.P.; Nunes, J.; Vieira, M.T. Thin films with chemically graded functionality based on fluorine polymers and stainless steel. Acta Biomater. 2008, 4, 1073–1080. [Google Scholar] [CrossRef] [PubMed]
- Piedade, A.P.; Pinho, A.C.; Branco, R.; Morais, P.V. Evaluation of antimicrobial activity of ZnO based nanocomposites for the coating of non-critical equipment in medical-care facilities. Appl. Surf. Sci. 2020, 513, 145818. [Google Scholar] [CrossRef]
- Piedade, A.P.; Dias, D.; Branco, R.; Morais, P.V. Unsaturated carbon linear chains created during bacteria incubation with amorphous carbon thin films produced by a clean technology. J. Clean. Prod. 2020, 249, 119363. [Google Scholar] [CrossRef]
- Piedade, A.P.; Veneza, C.; Duarte, C.B. Polyamide 6.6 thin films with distinct ratios of the main chemical groups: Influence in the primary neuronal cell culture. Appl. Surf. Sci. 2019, 490, 30–37. [Google Scholar] [CrossRef]
- Mo, S.; Mehrjou, B.; Tang, K.; Wang, H.; Huo, K.; Qasim, A.M.; Wang, G.; Chu, P.K. Dimensional-dependent antibacterial behavior on bioactive micro/nano polyetheretherketone (PEEK) arrays. Chem. Eng. J. 2020, 392, 123736. [Google Scholar] [CrossRef]
- Carman, M.L.; Estes, T.G.; Feinberg, A.W.; Schumacher, J.F.; Wilkerson, W.; Wilson, L.H.; Callow, M.E.; Callow, J.A.; Brennan, A.B. Engineered antifouling microtopographies—Correlating wettability with cell attachment. Biofouling 2006, 22, 11–21. [Google Scholar] [CrossRef]
- Bazaka, O.; Bazaka, K.; Khan, V.; Truong, V.K.; Levchenko, I.; Jacob, M.F.; Estrin, Y.; Lapovok, R.; Chichkov, B.; Fadeeva, E.; et al. Effect of titanium surface topography on plasma deposition of antibacterial polymer coatings. Appl. Surf. Sci. 2020, 521, 146375. [Google Scholar] [CrossRef]
- Pegalajar-Jurado, A.; Easton, C.D.; Crawford, R.; Mcarthur, S.L. Fabrication of a platform to isolate the influences of surface nanotopography from chemistry on bacterial attachment and growth. Biointerphases 2015, 10, 011002. [Google Scholar] [CrossRef] [PubMed]
- Cuello, E.A.; Mulko, L.E.; Barbero, C.A.; Acevedo, D.F.; Yslas, E.I. Development of micropatterning polyimide films for enhanced antifouling and antibacterial properties. Colloids Surf. B. 2020, 188, 110801. [Google Scholar] [CrossRef]
- Ferreira, S.; Piedade, A.P. Influence of Extracellular Mimicked Hierarchical Nano-Micro-Topography on the Bacteria/Abiotic Interface. Polymers 2020, 12, 828. [Google Scholar] [CrossRef]
- Zhang, X.; Zhang, Q.; Yan, T.; Jiang, Z.; Zhang, X.; Zuo, Y.Y. Quantitatively predicting bacterial adhesion using surface free energy determined with a spectrophotometric method. Environ. Sci. Technol. 2015, 49, 6164–6171. [Google Scholar] [CrossRef] [PubMed]
- Lorenzetti, M.; Dogsa, I.; Stosicki, T.; Stopar, D.; Kalin, M.; Kobe, S.; Novak, S. The influence of surface modification on bacterial adhesion to titanium-based substrates. ACS Appl. Mater. Interfaces 2015, 7, 1644–1651. [Google Scholar] [CrossRef]
- Banerjee, I.; Pangule, R.C.; Kane, R.S. Antifouling coatings: Recent developments in the design of surfaces that prevent fouling by proteins, bacteria, and marine organisms. Adv. Mater. 2011, 23, 690–718. [Google Scholar] [CrossRef]
- Koduru, J.R.; Kailasa, S.K.; Bhamore, J.R.; Kim, K.; Dutta, T.; Vellingiri, K. Phytochemical-assisted synthetic approaches for silver nanoparticles antimicrobial applications: A review. Adv. Colloid Interface Sci. 2018, 256, 326–339. [Google Scholar] [CrossRef] [PubMed]
- Pishbin, F.; Mouriño, V.; Gilchrist, J.B.; McComb, D.W.; Kreppel, S.; Salih, V.; Ryan, M.P. Single-step electrochemical deposition of antimicrobial orthopaedic coatings based on a bioactive glass/chitosan/nanosilver composite system. Acta Biomater. 2013, 9, 7469–7479. [Google Scholar] [CrossRef]
- Kumar, V.; Jolivalt, C.; Pulpytel, J.; Jafari, R.; Arefi-Khonsari, F. Development of silver nanoparticle loaded antibacterial polymer mesh using plasma polymerization process. J. Biomed. Mater. Res. Part A 2013, 101, 1121–1132. [Google Scholar] [CrossRef]
- Giglio, E.; Cafagna, D.; Cometa, S.; Allegretta, A.; Pedico, A.; Giannossa, L.C.; Sabbatini, L.; Mattiolo-Belmonte, M.; Iatta, R. An innovative, easily fabricated, silver nanoparticle-based titanium implant coating: Development and analytical characterization. Anal. Bioanal. Chem. 2013, 405, 805–816. [Google Scholar] [CrossRef]
- Ahamed, M.; Karns, M.; Goodson, M.; Rowe, J.; Hussain, S.M.; Schlager, J.J.; Hong, Y. DNA damage response to different surface chemistry of silver nanoparticles in mammalian cells. Toxicol. Appl. Pharmacol. 2008, 233, 404–410. [Google Scholar] [CrossRef] [PubMed]
- Niskanen, J.; Shan, J.; Tenhu, H.; Jiang, H.; Kauppinen, E.; Barranco, V.; Picó, F.; Yliniemi, K.; Kontturi, K. Synthesis of copolymer-stabilized silver nanoparticles for coating materials. Colloid Polym. Sci. 2010, 288, 543–553. [Google Scholar] [CrossRef]
- Hazer, D.B.; Sakar, M.; Dere, Y.; Altinkanat, G.; Ziyal, M.I.; Hazer, B. Antimicrobial effect of polymer-based silver nanoparticle coated pedicle screws: Experimental research on biofilm inhibition in rabbits. Spine 2016, 41, E323–E329. [Google Scholar] [CrossRef]
- Li, L.; Deng, J.; Deng, H.; Liu, Z.; Li, X. Preparation, characterization and antimicrobial activities of chitosan/Ag/ZnO blend films. Chem. Eng. J. 2010, 160, 378–382. [Google Scholar] [CrossRef]
- Petkova, P.; Francesko, A.; Fernandes, M.M.; Mendoza, E.; Perelshtein, I.; Gedanken, A.; Tzanov, T. Sonochemical Coating of textiles with hybrid ZnO/chitosan antimicrobial nanoparticles. ACS Appl. Mater. Interfaces 2014, 6, 1164–1172. [Google Scholar] [CrossRef]
- Zahran, M.K.; Ahmed, H.B.; El-Rafie, M.H. Surface modification of cotton fabrics for antibacterial application by coating with AgNPs–alginate composite. Carbohydr. Polym. 2014, 108, 145–152. [Google Scholar] [CrossRef]
- Dubbas, S.T.; Kumlangdudsana, P.; Potiyaraj, P. Layer-by-layer deposition of antimicrobial silver nanoparticles on textile fibers. Colloids Surf. A 2006, 289, 105–109. [Google Scholar] [CrossRef]
- Carvalho, D.; Sousa, T.; Morais, P.V.; Piedade, A.P. Polymer/metal nanocomposite coating with antimicrobial activity against hospital isolated pathogen. Appl. Surf. Sci. 2016, 379, 489–496. [Google Scholar] [CrossRef]
- Lee, D.; Cohen, R.E.; Rubner, M.F. Antibacterial properties of Ag nanoparticle loaded multilayers and formation of magnetically directed antibacterial microparticles. Langmuir 2005, 21, 9651–9659. [Google Scholar] [CrossRef]
- Cometa, S.; Iatta, R.; Ricci, M.A.; Ferretti, C.; Giglio, E. Analytical characterization and antimicrobial properties of novel copper nanoparticle-loaded electrosynthesized hydrogel coatings. J. Bioact. Compat. Polym. 2013, 28, 508–522. [Google Scholar] [CrossRef]
- Rtimi, S.; Sanjines, R.; Pulgarin, C.; Kiwi, J. Effect of light and oxygen on repetitive bacterial inactivation on uniform, adhesive, robust and stable Cu-polyester surfaces. J. Adv. Oxid. Technol. 2017, 20, 20160178. [Google Scholar] [CrossRef]
- Mural, P.K.S.; Jain, S.; Madras, G.; Bose, S. Antibacterial membranes for water remediation with controlled leaching of biocidal silver aided by prior grafting of poly(ethylene imine) on to ozone-treated polyethylene. ChemistrySelect 2017, 2, 624–631. [Google Scholar] [CrossRef]
- Park, D.; Wang, J.; Klibanov, A.M. One-Step, painting-like coating procedures to make surfaces highly and permanently bactericidal. Biotechnol. Prog. 2006, 22, 584–589. [Google Scholar] [CrossRef] [PubMed]
- Haldar, J.; An, D.; Cienfuegos, L.A.; Chen, J.; Klibanov, A.M. Polymeric coatings that inactivate both influenza virus and pathogenic bacteria. Proc. Natl. Acad. Sci. USA 2006, 103, 17667–17671. [Google Scholar] [CrossRef]
- Haldar, J.; Weight, A.K.; Klibanov, A.M. Preparation, application and testing of permanent antibacterial and antiviral coatings. Nat. Protoc. 2007, 2, 2412–2417. [Google Scholar] [CrossRef]
- Hoque, J.; Akkapeddi, P.; Ghosh, C.; Uppu, D.S.S.M.; Haldar, J. A biodegradable polycationic paint that kills bacteria in vitro and in vivo. ACS Appl. Mater. Interfaces 2016, 8, 29298–29309. [Google Scholar] [CrossRef]
- Bastarrachea, L.J.; Goddard, J.M. Self-healing antimicrobial polymer coating with efficacy in the presence of organic matter. Appl. Surf. Sci. 2016, 378, 479–488. [Google Scholar] [CrossRef]
- Hunga, Y.; McLandsborougha, L.A.; Goddardb, J.M.; Bastarracheac, L.J. Antimicrobial polymer coatings with efficacy against pathogenic and spoilage microorganisms. LWT Food Sci. Technol. 2018, 97, 546–554. [Google Scholar] [CrossRef]
- Ungureanu, C.; Pirvu, C.; Mindroiu, M.; Demetrescu, I. Antibacterial polymeric coating based on polypyrrole and polyethylene glycol on a new alloy TiAlZr. Prog. Org. Coat. 2012, 75, 349–355. [Google Scholar] [CrossRef]
- Nautiyal, A.; Qiao, M.; Ren, T.; Huang, T.; Zhang, X.; Cook, J.; Bozack, M.J.; Farag, R. High-performance engineered conducting polymer film towards antimicrobial/anticorrosion applications. Eng. Sci. 2018, 4, 70–78. [Google Scholar] [CrossRef]
- Cheng, X.; Ma, K.; Li, R.; Ren, X.; Huang, T.S. Antimicrobial coating of modified chitosan onto cotton fabrics. Appl. Surf. Sci. 2014, 309, 138–143. [Google Scholar] [CrossRef]
- Martin, T.P.; Kooi, S.E.; Chang, S.H.; Sedransk, K.L.; Gleason, K.K. Initiated chemical vapor deposition of antimicrobial polymer coatings. Biomaterials 2007, 28, 909–915. [Google Scholar] [CrossRef] [PubMed]
- Zhao, J.; Ma, L.; Millians, W.; Wu, T.; Ming, W. Dual-functional antifogging/antimicrobial polymer coating. ACS Appl. Mater. Interfaces 2016, 8, 8737–8742. [Google Scholar] [CrossRef] [PubMed]

Publisher’s Note: MDPI stays neutral with regard to jurisdictional claims in published maps and institutional affiliations. |
© 2020 by the authors. Licensee MDPI, Basel, Switzerland. This article is an open access article distributed under the terms and conditions of the Creative Commons Attribution (CC BY) license (http://creativecommons.org/licenses/by/4.0/).
Share and Cite
Pinho, A.C.; Piedade, A.P. Polymeric Coatings with Antimicrobial Activity: A Short Review. Polymers 2020, 12, 2469. https://doi.org/10.3390/polym12112469
Pinho AC, Piedade AP. Polymeric Coatings with Antimicrobial Activity: A Short Review. Polymers. 2020; 12(11):2469. https://doi.org/10.3390/polym12112469
Chicago/Turabian StylePinho, Ana C., and Ana P. Piedade. 2020. "Polymeric Coatings with Antimicrobial Activity: A Short Review" Polymers 12, no. 11: 2469. https://doi.org/10.3390/polym12112469
APA StylePinho, A. C., & Piedade, A. P. (2020). Polymeric Coatings with Antimicrobial Activity: A Short Review. Polymers, 12(11), 2469. https://doi.org/10.3390/polym12112469
